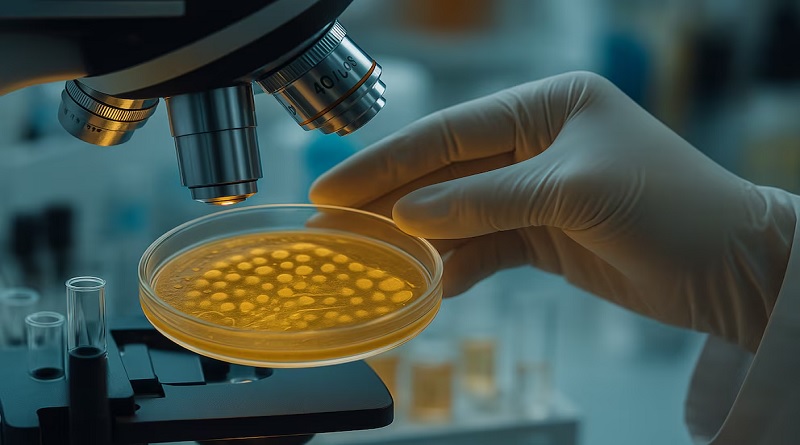

ANMAT y SENASA alertaron por una bacteria en un queso de consumo masivo: riesgos, lote afectado y las recomendaciones
La Administración Nacional de Medicamentos, Alimentos y Tecnología Médica (ANMAT) emitió una advertencia dirigida a la población tras la detección de Listeria monocytogenes en un lote específico de queso de pasta blanda Cremón doble crema, marca La Serenísima. Aunque el producto ya se encuentra fuera de su período de aptitud, la autoridad sanitaria subrayó que persiste un riesgo residual para quienes hayan conservado el queso más allá de su fecha de vencimiento, especialmente mediante congelación, lo que podría afectar a personas inmunosuprimidas y mujeres embarazadas.
En el marco de la vigilancia genómica realizada por el Laboratorio Nacional de Referencia de la Administración Nacional de Laboratorios e Institutos de Salud “Dr. Carlos G. Malbrán”, se identificó un conglomerado de casos vinculados a muestras de queso de pasta blanda remitidas por el laboratorio del Servicio Nacional de Sanidad y Calidad Agroalimentaria (SENASA).
El informe técnico de SENASA, fechado el 9 de diciembre de 2025, detalló que la bacteria fue hallada en el producto Cremón doble crema, peso neto 500 g, lote 2703, elaborado el 3 de julio de 2025 y con vencimiento el 11 de septiembre de 2025, producido por el establecimiento B-I-05184 de la firma MASTELLONE HNOS S.A., ubicado en Ruta nacional 5, Km 444, Trenque Lauquen, provincia de Buenos Aires.

Bajo la supervisión de SENASA, la empresa llevó a cabo una investigación interna para identificar el foco de contaminación y procedió a su eliminación, según se desprende de un comunicado.
Además, realizó el recupero de los quesos correspondientes al lote 2703 en todo el mercado nacional, con su posterior destrucción, e implementó medidas adicionales de control para evitar nuevos incidentes.
La ANMAT recordó que la Listeriosis es una enfermedad causada por el consumo de alimentos contaminados con la bacteria Listeria monocytogenes, la cual puede encontrarse tanto en el agua como en el suelo y tiene la capacidad de crecer incluso a temperaturas de refrigeración, aunque se elimina mediante la cocción.
Los alimentos más frecuentemente implicados en brotes de esta enfermedad incluyen fiambres y embutidos de carnes y aves, lácteos elaborados con leche sin pasteurizar, vegetales crudos y pescados crudos o ahumados.
La sintomatología de la Listeriosis puede variar desde escalofríos, fatiga, náuseas, vómitos, fiebre, dolor de cabeza, diarrea y dolor abdominal, hasta formas más graves como meningitis, septicemia y abortos en mujeres embarazadas. El período máximo de incubación de la bacteria es de setenta días, con un promedio de tres semanas.

La ANMAT recomendó que quienes tengan en su poder el lote 2703 del queso Cremón doble crema, peso neto 500 g, ya sea fraccionado o congelado, se abstengan de consumirlo.
¿Qué es la listeriosis?
Según informan desde la ANMAT, La listeriosis es una infección producida al ingerir alimentos contaminados con la bacteria Listeria monocytogenes, un microorganismo que puede encontrarse tanto en el agua como en el suelo. Esta bacteria tiene la capacidad de desarrollarse a temperaturas bajas, como las de los refrigeradores, aunque se elimina al cocinar los alimentos.
¿Qué alimentos pueden transmitirla?Algunos animales pueden portar la bacteria en su tracto intestinal sin mostrar síntomas, lo que puede dar lugar a la contaminación de productos cárnicos y lácteos derivados de estos animales. Los alimentos comúnmente asociados con brotes incluyen:
Fiambres y embutidos preparados con carne o aves.
Productos lácteos elaborados a partir de leche no pasteurizada.
Verduras frescas.
Pescado crudo o ahumado.
¿Cómo se puede prevenir? Recomendaciones básicas:
Higiene
Lavarse las manos con agua y jabón durante al menos 20 segundos antes y después de manipular alimentos.
Limpiar bien todos los utensilios de cocina y superficies que hayan tenido contacto con alimentos frescos, como mesadas, cuchillos o tablas para picar.
Lavar todos los vegetales crudos antes de su consumo.
¿Cuáles son los síntomas?

Los signos de la listeriosis pueden presentarse de distintas maneras. Incluyen escalofríos, sensación de cansancio, malestar estomacal, vómitos, fiebre, dolor de cabeza, molestias abdominales y diarrea. En cuadros graves, la enfermedad puede evolucionar hacia infecciones como meningitis o septicemia, así como provocar abortos en mujeres embarazadas. El tiempo que transcurre entre el contagio y el inicio de los síntomas puede ir desde 12 horas hasta 2 meses.
¿Quiénes corren mayor peligro de enfermar?No todas las personas que consumen alimentos contaminados desarrollan la infección. La posibilidad depende de la condición y la salud de cada individuo. Los grupos con mayor vulnerabilidad incluyen embarazadas, recién nacidos, adultos mayores y quienes tienen un sistema inmune debilitado (personas con VIH, cáncer o que reciben medicación inmunosupresora, entre otros). Las mujeres embarazadas también pueden transmitir la listeriosis a sus bebés a través de la placenta, con riesgo de parto prematuro, aborto o alteraciones en el recién nacido.
FUENTE : INFOBAE